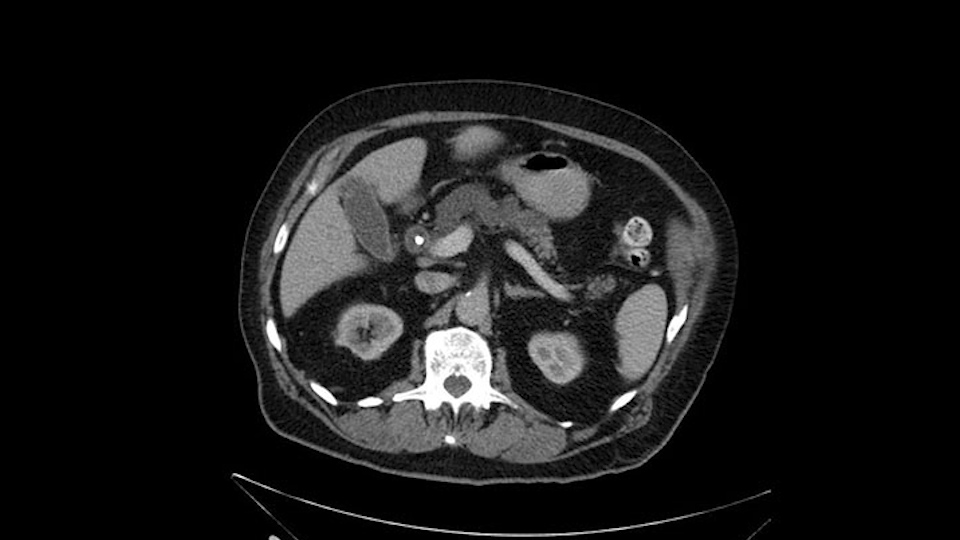
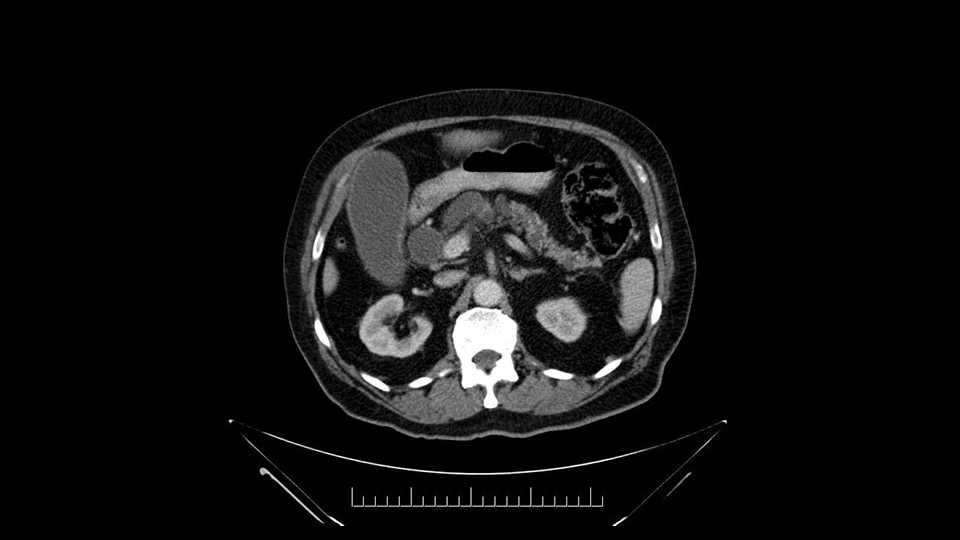
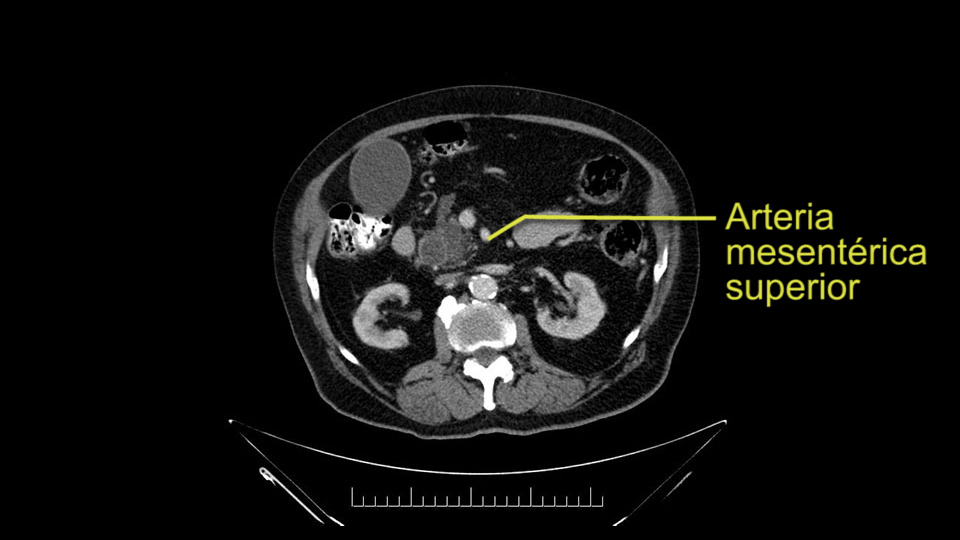

International Hepato-Pancreato-Biliary Association
Whipple (pancreaticoduodenectomy) [case 7]
Surgeon's Impressions
Watch the following videos of the surgeons preoperative plans for the case. Compare their findings with your own analysis.
Dr. Moulton's critical imaging findings:
Cystic lesions in pancreas head and neck
IPMN (Intraductal Papillary Mucinous Neoplasms)
Adipose tissue
My name is Carol-anne Moulton, I’m an associate professor here at University Health Network and I want to present to you a case of an 83-year old gentleman. We are planning on doing a relatively routine Whipple procedure.
He has no liver metastases or obvious metastatic disease. On reviewing his CT scan, he has normal vascular anatomy; he has no involvement of the portal vein by the looks of it, or the superior mesenteric vein.
He has normal arterial anatomy: no accessory or replaced right hepatic artery, which is important because sometimes the right hepatic artery can come behind the neck of the pancreas and you have to be careful of that in a Whipple dissection.

The only difference with him is that he has fairly extensive cystic lesions throughout his pancreas, particularly in the head and the neck. We have thought how this might affect the procedure. Likely IPMN (Intraductal Papillary Mucinous Neoplasms), and we have thought how this might affect the procedure. Is this a pancreatic adenocarcinoma rather than an ampullary cancer? The ampulla (of Vater) was abnormal on a side-viewing scope and a biopsy of this ampulla was adenocarcinoma. So I don’t think this was just a mass invading into the duodenum.

Number two, the reason why I think this IPMN might affect the procedure: it is involving the neck. So normally when we come across the neck, we would like to see a normal pancreas with a small or a large duct but you can see on the scan that this is fairly extensive duct and cystic lesion at that point. The only slowing down moment for me is really that. Coming across the pancreas, then wanting to see what that looks like and how that is going to affect my anastomosis.
He’s got a lot of adipose tissue which I know is going to make the operation more difficult. From a co-morbid point of view, after some discussion, we thought that it would be best to leave pancreas with IPMN and remove the tumor - rather than try to do a subtotal pancreatectomy and try to get all of this IPMN out - so that’s what we plan on doing.
Dr. Gallinger's critical imaging findings:
Dilated pancreatic duct
First jejunal branches of SMV
It's Steve Gallinger. I’m a professor of surgery at the University of Toronto and surgical oncologist here at UHN. I’m looking at the preoperative imaging of a periampullary cancer in an older gentleman about to undergo a Whipple operation.
So when I’m assessing a CT scan for a presumed periampullary cancer, either pancreatic or otherwise, of course you want to look at some of the big picture items: metastatic disease, invasion of the mesentery at the root. I’m not looking for them here because it's a small tumor and we’re reliant on the radiologist to report these so I usually look at the report.
Anyhow. What the surgeon does need to do though, is focus on the resection. What I generally do is look at the tumor, which is here, and then I look at the nature of the pancreas. That’s really just to get an idea on what it would be like to do the pancreatic anastomosis, which isn’t technically the biggest deal, but it’s the biggest deal for the patient afterwards; and the larger the duct and the harder the pancreas, the less likely it’s going to leak. Leaks are what cause almost all the morbidity so I do think of it mentally. I wouldn’t do anything differently, the night before or the morning or the surgery or during the surgery, but certainly mentally it’s useful to know that you may have a challenge in terms of doing the best pancreatic anastomosis you can. I think the duct is quite large. The interesting thing about the duct: it does peter out into fairly normal looking pancreas; that’s a bit strange. But I’ll assume the duct is large.
The next item that I would look at: the issue would be the vessels and usually start at the portal vein, watch the portal vein, follow it down, down-down-down to the neck of the pancreas - which is here - and there’s no impingement by tumor, which is great. The SMV and the splenic vein, which is here. The splenic vein junction is normal, which is great.
Then look at the first jejunal branch - which is this thing here - this little branch which goes under the SMA. It’s something that we’ve just started appreciating over the past few years and the reason for that is: there’s two or three small branches that come out of the uncinate into the the first jejunal and it’s a fairly inevitable part of the operation where there’s some bleeding. As long as you’re cognizant of what’s happening, it’s no reason to panic and that kind of bleeding will eventually stop or can be stopped but it’s not easy because these little vessels are fragile from the uncinate to the first jejunal. So I do focus on that and it’s pretty consistent I’d say 9 times out of 10, people have that first jejunal.
The other thing I look at is the gastroepeiploic arcade- which is this thing here- which is where the gastroepeiploic vein joins the portal vein. I call it the gateway to the neck of the pancreas because you pretty much have to divide it to get to the neck. The middle colic vein usually drains either into it or nearby. I think we’re seeing it here. Again,that can be divided and I usually divide those two and it helps me get under the neck. Again, there’s no issues here with the tumor so it’s nice from that perspective. If I was concerned about the vein, which I’m not here, I would go to the coronal view. It’s a nice way to look at the vein on just a couple of cuts and you can see a beautiful view of it here. There’s the portal vein, there’s the head of the pancreas. There’s the tumor. It’s a little closer here than it looks on the other one. I doubt it’s involved. If it’s touching, it may not be invading it but even if it was, it's a short segment. Anyways, there’s the SMV there’s the splenic vein, and everything looks good. You can see the stent. I ignore the stent. It’s the most dramatic looking thing in the picture but it’s actually the least important.

Then either through the coronal or the axial, I’ll do both. Look at the SMA -which is here- I had already looked at it and I don’t see any involvement. There’s the SMA with a nice fat plane between the SMA and the tumor. Over here you can see on the axial, there’s the SMA. Everything on the right side of the SMA has got some nice black around it, which is fat, which means probably no tumor [no tumor, no tumor]. Follow it up to the origin, coming off the aorta. So those are the two technical things that I worry about: the SMA and the SMV.

Then you look for anomalies. The one you worry about the most doing a Whipple is a replaced or aberrant right hepatic artery coming off the SMA at its origin. So again, find the SMA. You can find it because the renal vein goes through it. Follow it up, up-up-up. Nothing coming off of there that I can see here. Nothing coming off of it, nothing coming off of it and just to confirm it, look at the celiac trfurcation. There’s the celiac, there’s the bifurcation, there's the splenic artery, hepatic artery. Make sure there’s a right, which there is here. The right usually goes under the bile duct: important when you’re going around the bile duct to do a Whipple. A replaced right goes under the portal vein and the bile duct way over here on the right. That’s about it.
Dr. Shailesh Shrikhande’s critical imaging findings:
Atherosclerotic changes
Pylorus-preserving pancreatoduodenectomy
Dilated pancreatic duct
Assess for IPMN
My name is Dr. Shailesh V Shrikhande. I’m the Chief of GI and HPB cancer surgery at the University Hospital in Mumbai at the Tata Memorial Hospital. It is India’s largest cancer hospital.
The patient that is being discussed just now is an 83-year old gentleman with obstructive jaundice with a biopsy-proven ampullary cancer, adenocarcinoma with very raised and high levels of bilirubin. What has been presented to me has been an axial and coronal images of the CT scan prior to the stenting 3 months ago. It’s a periampullary tumor as per the CT scan assessment that I have done. And then the CT scans have been repeated again. The patient did undergo an ERCP with what I suppose is a plastic stent and not a self-expandable metal stent.
The following issues that stand out to me in my mind when I look at the CT scan over here, is that I anticipate a degree of inflammation because this patient has had an ERCP with a stent following a sphincterotomy but that’s 3 months ago so the inflammation should not be a major source of concern.
This gentleman is 83 years of age and so I anticipate a gentle friability of tissues because he’s not a young patient. I do not know whether the patient is a diabetic or a hypertensive or a history of alcohol. But there is no obvious evidence of a cirrhotic liver in this gentleman. Neither do I find a large caudate lobe to suggest portal hypertension. Neither do I see presence of abnormal collaterals or splenomegaly.
The gastroduodenal artery, a major artery that we have to divide, along with some pancreatoduodenal arteries, may have atherosclerotic changes so they would have to be handled with care, when I attempt what I think would be a pylorus-preserving pancreatoduodenectomy would be the plan. In some cases, I might make an intraoperative change and do a partial antrectomy or a pylorus-resecting Whipple, should the need arise for technical reasons but not because of the size of the tumor.
I see a dilated biliary system but I also see a dilated pancreatic ductal system which is almost looking cystic in the head and neck region of the body. When I tackle the neck of the pancreas during the course of the surgery, I would have to pay particular attention to the neck of the pancreas when I transect it, to see for any changes of associated IPMN. They may not be IPMN but the thing is there is dilatation and that’s why I need to be careful, with the consideration for intraoperative frozen section for the pancreatic neck margin.

With this in place, I see atherosclerotic changes in the aorta which are again age-related but otherwise, I anticipate that this patient should do well for what should be an uneventful Whipple resection or a pancreatoduodenectomy.
Now the procedure-specific slowing down moments that I would do in this gentleman is that there are two things. One is to plan the incision. Sometimes we may do a bilateral subcostal incision, many a-times we would prefer a midline incision if we are doing an open Whipple resection. Given the age of this patient and given my experience, I would rather prefer to do an open Whipple resection rather than a laparoscopic Whipple resection - which technically also looks feasible in this man.
So initially I would be careful to understand the individual friability of tissues in any patient, in any operation, irrespective of the age of the patient.
In planning for my further steps, the first key that I find, first do a gentle mobilization of the hepatic flexure of colon completely away because that’s going to help me do a good wide Kocher maneuver. Why do I slow down? Because there are small tributaries and small blood vessels which communicate between the transverse mesocolon and the head of the pancreas and you also have the loop of Henle all the blood vessels which drain into the superior mesenteric vein just as it gets underneath the neck of the pancreas.
The initial hepatic flexure mobilization and the Kocher procedure is then going to enable me to understand the uncinate process of this patient, which should not be a problem, again. But the initial pictures had shown a degree of touching. I would not even say involvement or abutment; a degree of touching with the superior mesenteric vein. So that would give me an early chance to assess how the superior mesenteric vein is in this patient. So this would be the initial slowing down moment.
The other slowing down moment would be the gastroduodenal artery. Confirming that the gastroduodenal artery is not a dominant artery supplying blood to the liver. Liver failure is something which we don’t want due to altered blood supply to the liver or hampered arterial blood supply to the liver. So I would dissect out the hepatic artery, the left and right branches very clearly. Put a bulldog clamp on the gastroduodenal artery, make sure that the perfusion of the liver is excellent on the right and left side, and then divide the gastroduodenal artery. I would avoid using crushing instruments or crushing clamps on the gastroduodenal artery because they have a tendency to shatter in patients who are old with friable vessels so you have to be careful and tackle it with the help of a 5-0 or a 6-0 prolene sutures. In younger patients, I would just apply clips and move on when it comes to dividing the gastroduodenal artery.

The other area of concern would be the pancreatic neck. I would expect a dilated pancreatic duct, but I would send the margin, after I’m doing my resection, to assess the status of the pancreatic neck and make sure there is no mild or moderate dysplasia at the neck, or no associated features of IPMN. Though we have an ampullary proven adenocarcinoma.
The other area of concern, as always, would be a pancreas anastomosis. But again, if the surgery is moving very well, if the blood loss is under control right from the beginning, if all the major relevant steps of a Whipple procedure are followed carefully, I expect an R0 resection. I do not expect abnormal areas of bleeding in this patient. I expect an easy bile duct anastomosis because it’s a dilated bile duct and a fairly safe pancreatic duct anastomosis also because the pancreatic duct is fairly dilated. But they would still require gently handling, considering the age of the patient and the general atrophy of the pancreas that I see are on the CT scan.
Procedure-specific moments:
Laparotomy to rule out metastases
Assess resectability of lesion
Check for celiac trunk stenosis: SMA, hepatic arteries
Clamp GDA: check for hepatic arterial pulse/inflow
Right hepatic artery branch
No portal venous invasion: PV, SMV
Patient-specific moments:
Dilated Wirsung duct
Resection margin at isthmus: frozen section biopsy
Dissection of uncinate process
My name is Oscar Guevara, I am a Professor of Surgery in the Department of Surgery of the National University of Colombia and I am an HPB Surgeon at the National Institute of Cancerology in Bogotá, Colombia.
The patient that we are reviewing, is an 83-year-old patient, who presented with jaundice and received a biliary stent that helped relieve his jaundice. The patient was found to have a visible lesion in the ampulla of Vater, which was biopsied and an adenocarcinoma was diagnosed.
Despite his age, he appears to be in good physical condition, therefore once his cardiovascular condition and comorbidities are fully evaluated; this patient would be a candidate for a pancreatoduodenectomy procedure.
What findings can change the intraoperative plan?
Of course, the first step is to rule out distant metastases. So at the beginning, we carefully evaluate by inspection or palpation- and hopefully with operative ultrasound. The liver and the peritoneum should also be checked to rule out peritoneal carcinomatosis.
Next we evaluate and confirm the resectability of the lesion, especially in cases of adenocarcinoma of the pancreas. We know that the vessels could be compromised. In this patient we do not expect that to happen, but that could lead to a change in the approach.
To plan a pancreatoduodenectomy, we start by reviewing the vascular anatomy, especially the origin of the celiac trunk, here, in front of the aorta, looking for any evidence of stenosis. In addition, we look at the origin of the superior mesenteric artery, to look for any branches, and any replaced right hepatic arteries coming from the superior mesenteric artery; which does occur in about 12% of the population.


Important points to keep in mind during a pancreatoduodenectomy:
First, the stenosis of the celiac trunk, which can be caused by arteriosclerosis, especially in a patient who is 83, or in patients who have arcuate ligament; we do see it, sometimes in much younger patients. In those cases, it may be that the circulation of the hepatic artery comes entirely from the gastroduodenal artery and its anastomoses, through the pancreaticoduodenal arteries, coming from the superior mesenteric artery. This means that before the gastroduodenal artery is ligated, we first clamp and wait 30 seconds to a minute, to feel and check the arterial inflow to the liver. If the pulse is diminished or there is a complete absence of the pulse, the surgery should be modified or probably a pancreatoduodenectomy cannot be done, because of the risk - when ligating the gastroduodenal artery - of causing fulminant hepatic ischemia postoperatively.
The second point about the vascular anatomy-, is to again look for right hepatic arteries in the hilum, coming from the superior mesenteric artery by palpating-through the Winslow Hiatus. Usually we will check for a pulse in the posterior aspect of the hepatic hilum, where a right hepatic artery should not usually be found. In this case, the precaution is to avoid an accidental ligation of the right hepatic artery that might jeopardize perfusion of the right lobe, or if there is a completely replaced hepatic artery that can put the liver circulation at risk.

The next thing we always evaluate, although we do not expect invasion to the portal veins in this case, we must always trace the path of the portal vein, in both directions, from top to bottom. The splenoportal confluence and the superior mesenteric vein, which in this case does not appear to be compromised.



When reviewing the images of this patient, it is striking that there is a large dilation of the Wirsung duct, which is unusual in patients with carcinoma of the ampulla of Vater, and the dilatation in the head of the pancreas has almost replaced all the parenchyma, therefore there is a significant suspicion that the patient has an intraductal papillary mucinous tumor of the pancreas. It’s possible that it's a result of the same pathology and what we are seeing at the ampulla of Vater is the protrusion - because the pancreatic ducts are full of mucus; but we have a biopsy of adenocarcinoma, which could be a malignant degeneration, of an intraductal papillary mucinous tumor or a coincidence pathology, in addition to adenocarcinoma of the ampulla of Vater. Either way, if this patient is having surgery, the decision would be a pancreatoduodenectomy, But we should consider the possibility that the patient might have a intraductal papillary mucinous tumor of the pancreas.


The other precaution at the time of surgery, is the transection at the level of the isthmus of the pancreas; in this case we must do a frozen section biopsy where basically we will check the margin for adenocarcinoma or if there is dysplasia, and if it is low or high grade. If the dysplasia is high grade, the recommendation is to take the margin of resection further left and distal, until a biopsy is obtained with no high-grade dysplasia or adenocarcinoma.

Other important points are: the dissection of the uncinate process which must be done very carefully, the ligation of the venous branches there, and looking for the inferior pancreaticoduodenal arteries coming from the superior mesenteric artery during the dissection of the uncinate process.

In this 83-year-old patient, we would probably not recommend a total pancreatectomy because of the increased difficulty for postoperative management.
Puntos importantes durante la chirurgia
Descartar metástasis y carcinomatosis peritoneal
La resecabilidad misma de la lesión
Revisar la estenosis del tronco celíaco: las arterias mesentérica superior y hepáticas
Clampar la arteria gastroduodenal: evaluar el pulso en la arteria hepática
Evaluar la presencia de una artera hepática accesoria
No invasión de los vasos portales
Puntos importantes en este paciente
Dilatación del conducto de Wirsung
Sección del istmo del páncreas: hacer una biopsia del margen
Disección del proceso ulcinado
Mi nombre es Oscar Guevara, soy Profesor de Cirugía en el Departamento de Cirugía de la Universidad Nacional de Colombia y soy Cirujano de Hígado, Vías Biliares y Páncreas en el Instituto Nacional de Cancerología en Bogotá, Colombia.
Este paciente que estamos revisando, es un paciente de 83 años, quien consulta por ictericia, fue tratado ya con un stent biliar; mejoró la ictericia y tiene una lesión visible en la ampolla de Vater, con una biopsia que indica un adenocarcinoma.
A pesar de la edad, de los 83 años, aparenta estar en buen estado, en buena condición física, por lo cual, una vez sea evaluado completamente su condición cardiovascular, sus comorbilidades; este paciente sería candidato a realizar una pancreatoduodenectomía.
¿Qué hallazgos pueden hacer cambiar el plan durante la cirugía? Por un lado descartar metástasis a distancia, por lo cual, al comenzar la cirugía evaluamos muy bien -por inspección o palpación- y ojalá con ecografía operatoria, el hígado, el peritoneo -también debe ser revisado- para descartar carcinomatosis peritoneal.
El siguiente paso es evaluar la resecabilidad misma de la lesión, sobre todo en los casos de adenocarcinoma del páncreas; sabemos que pueden estar comprometidos los vasos. En este paciente no esperamos que eso ocurra, pero eso podría llevar a cambiar la conducta.
Para planear una pancreatoduodenectomía, se debe revisar la anatomía vascular, especialmente el origen del tronco celíaco, aquí, por delante de la aorta, buscando areas de estenosis y por otro lado, el origen de la arteria mesentérica superior, para evaluar -sobre todo- si hay ramas, arterias hepáticas derechas provenientes de la mesentérica superior; lo cual ocurre en alrededor del 12% de la población.


Puntos importantes a tener en cuenta durante la pancreatoduodenectomía:
La primera que mencionamos, la estenosis del tronco celíaco, que puede ser causada por arterioesclerosis, especialmente en este paciente de 83 años, ó por pacientes que tienen ligamento arcuato; ese sí lo vemos, a veces, en pacientes mucho más jóvenes. En esos casos, puede resultar que la circulación de la arteria hepática provenga completamente a través de la arteria gastroduodenal y sus anastomosis, por las arterias pancreaticoduodenales, provenientes de la mesentérica superior.
Esto quiere decir la precaución que tenemos, es que -antes de ligar la arteria gastroduodenal- durante la pancreatoduodenectomía, hacemos un clampeo, esperamos 30 segundos o un minuto, y palpamos y vemos el pulso hepático. Si el pulso hepático se disminuye o hay ausencia completa del pulso, debe modificarse la cirugía; probablemente no se pueda hacer la Pancreatoduodenectomía, por el riesgo -al ligar la arteria gastroduodenal- de causar una isquemia hepática fulminante en el postoperatorio.
E l segundo punto de la anatomía vascular, es nuevamente buscar arterias hepáticas derechas, en el hilio, provenientes de la mesentérica superior y eso lo hacemos palpando -a través del Hiato de Winslow- el hilio hepático y usualmente sentiremos un pulso en el aspecto posterior del hilio hepático, donde no debe ir el recorrido usual de la rama derecha de la arteria hepática. En este caso, la precaución es no realizar una ligadura accidental de la arteria hepática derecha y poner en riesgo -posiblemente- la perfusión del lóbulo derecho, o aún esta arteria puede reemplazar completamente la arteria hepática y poner en riesgo la circulación del hígado.

Por otro lado, siempre evaluamos -aunque en este caso no esperamos que haya invasión de los vasos portales-, siempre hay que hacer el recorrido de la vena porta, en ambos sentidos, de arriba hacia abajo; el confluente esplenoportal y la vena mesentérica superior, que en este caso no aparentan estar comprometidos.



Al revisar las imágenes de este paciente, llama la atención que tiene una gran dilatación del conducto de Wirsung, lo cual no es usual en los pacientes con carcinoma de la ampolla de Vater, a nivel de la cabeza del páncreas- casi que ha reemplazado el parénquima. También podría ser que esa sea su única patología y que lo que estamos viendo desde la ampolla de Vater, sea la protrusión -por estar lleno de moco- los conductos pancreáticos; pero tenemos una biopsia de adenocarcinoma, que podría ser una degeneración maligna, ya del tumor papilar intraductal mucinoso ó una coincidencia de tener esta patología, adicional a un adenocarcinoma de la ampolla de Vater. En ambos casos, si este paciente es apto para cirugía, la conducta sería una pancreatoduodenectomía, pero teniendo en cuenta que probablemente si tenga el paciente un tumor papilar intraductal mucinoso del páncreas.

La otra precaución que tener en el momento de la cirugía, es el nivel de sección del istmo del páncreas; en este caso sí debemos hacer una biopsia por congelación, donde básicamente vamos a evaluar si hay adenocarcinoma en ese sitio ó si hay una displasia, y si ésta es de bajo o de alto grado. Si la displasia es de alto grado, la recomendación es aumentar el margen de resección hacia la izquierda y hacia el lado distal del páncreas, hasta obtener una biopsia donde no haya displasia de alto grado, ni adenocarcinoma.

Otros puntos importantes por supuesto son: la disección del proceso uncinado, que debe ser muy cuidadosa, la ligadura de las ramas venosas, la búsqueda de la arteria pancreaticoduodenal inferior, proveniente de la arteria mesentérica superior, durante la disección del proceso uncinado.
En este paciente de 83 años, probablemente no estaríamos recomendando una Pancreatectomía total por la alta dificultad para el manejo postoperatorio.
Patient-specific moments:
No metastatic disease or vascular invasion
Need to evaluate extent of dilated pancreatic duct
Suspicious for main duct IPMN
Procedure-specific moments:
Check for metastatic disease
Determine tumor proximity to major vessels
SMV dissection at pancreatic neck
Pylorus-preservation
Confirm arterial anatomy: RHA, GDA
Pancreatic neck margin
Uncinate margin, IPDA
My name is Keith Lillemoe. I'm a Professor of Surgery at the Harvard Medical School and the Chief of Surgery and a pancreatic surgeon at the Massachusetts General Hospital in Boston.
I've been asked to look at the images and talk about the care of a patient who has a biopsy proven ampullary carcinoma. But he also has some interesting changes involving the proximal main pancreatic duct, which certainly could be consistent with a main duct IPMN involving the duct.
Looking at the C.T. scan, the most important thing to determine is, of course, does the patient have any evidence of metastatic or disseminated disease or locally advanced disease? The imaging shows dilated intrahepatic biliary tree but I don't see any signs of liver metastasis. As would be expected with a ampullary lesion there's no evidence of major visceral vessel invasion. So this patient would look to me to be a candidate for pancreaticoduodenectomy or Whipple procedure.
There is a bit of a challenge in my mind that will have to be determined intraoperatively and that's the extent of the pancreatic duct dilatation as you move from the head of the gland more distally into the body and tail. We certainly can see dilatation of the pancreatic duct in patients with ampullary carcinoma. But this seems a little bit unusual in terms of the extended dilatation. It also stops pretty dramatically at the body of the gland with the dilatation not extending to the tail. So again, raises the suspicion that this could be a main duct IPMN. The patient would not require any further preoperative imaging. I don't believe an endoscopic ultrasound is going to add anything to this patient's management. So I would take the patient to the operating room at this time. I would not perform a diagnostic laparoscopy, that's not my practice even for pancreatic cancers at least involving the head of the gland.
The first steps of a pancreaticoduodenectomy involve ensuring the CT findings are correct: exploring for signs of metastatic disease, peritoneal implants involving the omentum or the undersurface of the diaphragm and if again this is confirmed exploration that there's no metastatic disease, I begin the mobilization and really determining the relationship of the tumor with the major visceral vessels. I start by an extended Kocher maneuver, identify the superior mesenteric vein below the neck of the pancreas. They’re very thin walled vessels and as you're dissecting you have to use the ultimate care and meticulously dissect the superior mesenteric vein, ligate the anterior branches and begin the dissection from below to under the neck of the pancreas. At this point, if there's no reason to be concerned about whether there is any vascular invasion below, I usually take the gallbladder down. I mobilize the common hepatic duct above the insertion of the gallbladder. This patients already has a stent in place. So I would divide the bile duct at this point. This facilitates the dissection of the anterior surface of the portal vein and as I would expect looking at this imaging that there is nothing to be concerned about in terms of vascular involvement.
Without any concern about vascular involvement, once I've developed the plane underneath the neck of the pancreas and sort of connected the tunnel from above and below, I feel pretty comfortable the patients going to be resectable at this point.
I am a believer in pylorus preservation. And in this case I see no reason why that wouldn't be possible. Mobilize the duodenum, divide the gastroepiploic vessels and divide the duodenum. I try to divide it with a linear stapler about four centimeters from the pylorus to have adequate length for my GI anastomosis. This facilitates exposure of the head neck of the pancreas. I find the gastroduodenal artery. This patient has normal arterial anatomy. Always on every preoperative CT scan I look to see if there is a replaced right hepatic. In this case I did not see one. Regardless of how confident I am I always look carefully for variant anatomy. I always do a clamp test on the GDA before ligation. I doubly ligate the GDA with not just a tie but a suture ligature because of the risk of GDA blowout in patients with a leak.
After dividing the GDA you're really at the neck of the pancreas and in this case this is where the intraoperative decision making may be a little bit more challenging because as I mentioned, there's dilatation of the pancreatic duct well beyond the normal place where you would divide the pancreatic neck in a standard Whipple. So we would have to mobilize the patient further to the left, probably up to almost to the celiac axis or maybe even beyond as I look at this, it extends almost a centimeter or so into the splenic artery. You could take your chances on this, you could divide it and then do an intraoperative frozen section and at the time of intraoperative frozen section. If the pathologist says yes they see a main duct IPMN in the in the frozen section then I certainly would extend this further to the left until I was able to get far enough and back to normal pancreas. If this is normal ductal epithelium and the patient has a dilatation the pancreatic duct secondary to the ampullary obstruction, you could certainly make the operation technically easier by not extending that far to the left and be left with a generous pancreatic duct for your reconstruction. But I do think in this case, frozen section confirmation that you do not have a main duct IPMN will be essential to determine the extent of resection. I see no reason why this patient would be advised that they're going to need a total pancreatectomy. He does have a generous amount of gland in the body and tail but it will increase the technical difficulty of both resection and reconstruction to get to the left of where that dilatation ends.
Once the pancreatic neck is divided, you sort of roll or flip the neck of the gland over, exposing the anterior surface and the right lateral surface of the portal vein-SMV complex. Continue that dissection down. Oftentimes you can really continue your dissection right along the uncinate on the SMA. Again a little advantage of this patient having an ampullary lesion, there's likely to be no evidence of extension into the uncinate so you don't have to worry quite as much about the margin at the uncinate as you would with a pancreatic head cancer. Keeping in mind that you will have an inferior pancreatic duodenal artery in there that you want to try to identify and ligate individually. At some point along that time I go to the ligament of Treitz. Clean an area of the ligament of Treitz of its mesentery, divide it there with a linear stapler. I use the Harmonic scalpel to mobilize the proximal 10-inches or so of small intestine down to the ligament of Treitz completely mobilize the ligament of Treitz past the jejunal limb underneath the root of the mesentery and then carefully dissect the third and fourth portion of the duodenum’s mesentery as well as the remaining uncinate to complete my resection. I will have marked and sent frozen section from the pancreatic neck at the time that I do the resection of that part of the gland so that I have that information back by now. I would also probably get a margin on the uncinate and a margin on the bile duct just for completeness, although for an ampullary carcinoma that would be unlikely to have a positive extension.
At that time, I'm a believer in irrigation. Irrigate, check for bleeding, get hemostasis as good as you can and start my reconstruction. I'm a single limb reconstruction person. I bring the end of the jejunum up, do an end-to-side pancreaticoduodenectomy.
I tend to do the mucosal duct-to-mucosal-to-mucosal anastomosis through a small enterotomy.
I learned the technique late in my career of using external stents. If it's a small duct we’ll place a small pancreatic stent and exit it through the jejunal limb and out through the abdomen.
After completing the pancreatic anastomosis I do an end-to-side hepaticojejunostomy. A big duct like this, this should be relatively straightforward. I would probably use interrupted Vicryl for that anastomosis; having used 5-0 PDS for the pancreatic ductal anastomosis. As I mentioned I will do duodenojejonostomy using antecolic fashion.
Acknowledgements
Thank you to the HPB Surgeons who contribute their time and expertise. This content is made possible through educational grants from:
Case 28

Views and opinions expressed in all videos and module content are those of the individual surgeon and solely intended for surgical education purposes. We do not endorse any product, treatment or therapy.
Corporate Partners
If you are interested in becoming a Corporate Partner of the IHBPA please contact industry@ihpba.org
Find out more
 Go to myHPB
Go to myHPB




















